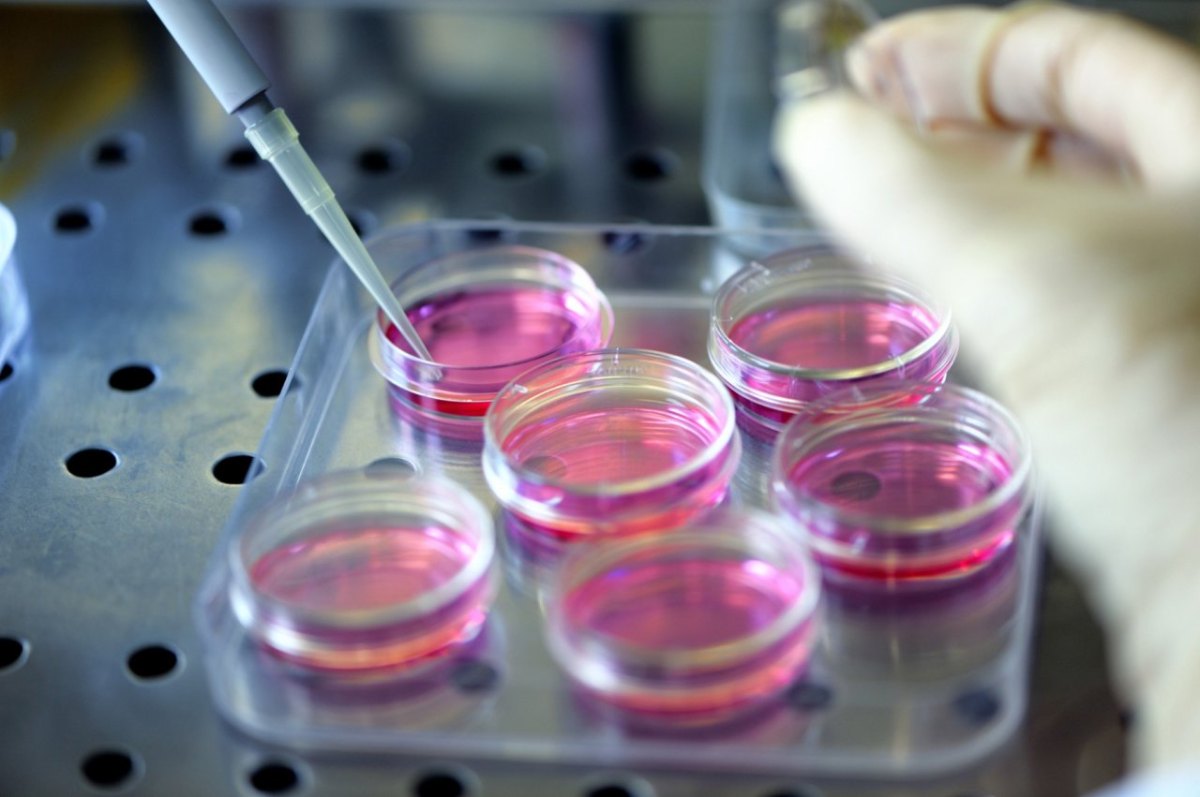
060712Ingo117.JPG

Düsseldorf.
Ein Gemisch aus Skepsis, Angst und dem St.Florians-Prinzip beim Einsatz neuer Techniken wird zum Problem in Deutschland, dem Land der Ingenieure – da sind sich Wirtschaft und Gewerkschaften einig. „Unser Wohlstand basiert auf technischen Leistungen“, mahnt der NRW-Chef des CDU-Wirtschaftsflügels, Hendrik Wüst.Auch Michael Vassiliadis, mächtiger Chef der Chemie- und Energiewerkschaft IGBCE, vermisst bei „Wutbürgern“ und Fortschrittskritikern eine Chancen- Risiko-Abwägung. Stets gehe es nur um mögliche Gefahren, fast nie um den möglichen Nutzen.
Nicht nur in der Pharma- und Chemieindustrie, so die Kritiker, mache sich ein De-Investitionsklima breit. Viele Pharma-Firmen und Forscher sind mit der Genforschung ins Ausland geflüchtet, weil die Biotechnologie in Deutschland einen schweren Stand hat.
Der Chemiekonzern Bayer verlegte seine Bluterforschung von Wuppertal in die USA, als die umstrittenen Tierversuche hier kaum noch durchsetzbar waren. Investitionen finden im Ausland statt, neue Ideen werden von einem innovationskritischen Immunsystem abgewehrt. Verliert Deutschland bei Zukunftstechnologien den Anschluss?
Mobilfunkmasten und Windräder
Das gilt jedenfalls für die Nanotechnologie und die embryonale Stammzellenforschung, die in den USA und Israel gegen weniger Widerstände und Ängste ankämpfen müssen. Gegner der Stammzellenforschung warnen vor den Gefahren „unreflektierter Fortschrittsgläubigkeit“. Die Folge: Forschung und Entwicklung von Zukunftsprojekten wandern ab.
Hohe Mobilfunk-Masten, Windräder, neue Gasleitungen, Gewerbegebiete, Flughäfen, Autohöfe, Straßen – oft gibt es massive Widerstände in der deutschen Wohlstandsgesellschaft. „Wir ruhen uns gerade auf unserer relativen Stärke aus“, fürchtet Wüst.
Gewerkschafter Vassiliadis sieht Anzeichen von Realitätsverweigerung: „Es gibt eine Innovations- und Produktionsskepsis, die nicht zusammenpasst mit der Exportweltmeisterschaft. Deutschland lebt von der Substanz.“ Neue Kraftwerke und Großprojekte errichten deutsche Anlagenbauer heute meist außerhalb der Landesgrenzen.
Deutschland, digitales Entwicklungsland
Bei den modernen Kommunikationstechniken ist Deutschland zum „digitalen Entwicklungsland“ abgerutscht. Während die Digitalisierung weltweit neue Zukunftsmärkte erobert, wartet der forschungsstarke Mittelstand in deutschen Randregionen immer noch auf die schnelle digitale Datenautobahn. Das Institut der Wirtschaft (IW) rechnet vor, dass die Beschleunigung von zehn Prozent des langsamen Breitbandnetzes mindestens 0,9 Prozent Wirtschaftswachstum bedeuten würde.
Aktueller Konfliktpunkt ist das Freihandelsabkommen TTIP zwischen Europa und den USA. Die Deutschen fürchten, dass europäische Sozial- und Umweltstandards auf US-Niveau abgesenkt würden. Bei allen Problemen mit TTIP erinnert Wirtschaftsmann Wüst aber auch an die Chancen.
Hinweis auf die „5“ in Mathe
So würde nicht nur der deutsche Autoexport profitieren: „Es geht um mehr als die Vereinbarung auf gemeinsame Standards wie einheitliche rote Rückleuchten.“ Die TTIP-Kritiker haben sich breit aufgestellt – es steht nicht fest, ob das Freihandelsabkommen 2015 überhaupt noch unterzeichnet wird.
Gewerkschafter Vassiliadis blickt skeptisch auf die Zukunftsorientierung. Noch würden industrielle Anlagen in Deutschland effizient genutzt: „Aber es kommen kaum neue hinzu und selbst der Ersatz veralteter Anlagen wird auf Kante gefahren.“ Dabei sei der Erfolg von morgen das Ergebnis der Investitionen von heute, weiß Vassiliadis. Energieintensive Unternehmen haben ihre Re-Investitionen in Deutschland inzwischen auf 85 Prozent heruntergefahren.
Noch ist der Hinweis auf die „5“ in Mathe ein guter Party-Gag. An den Schulen fristen Fächer wie Physik, Chemie und Biologie oft ein Schattendasein. Unwissen aber sei ein guter Nährboden für Ängste, mahnen Wissenschaftler.